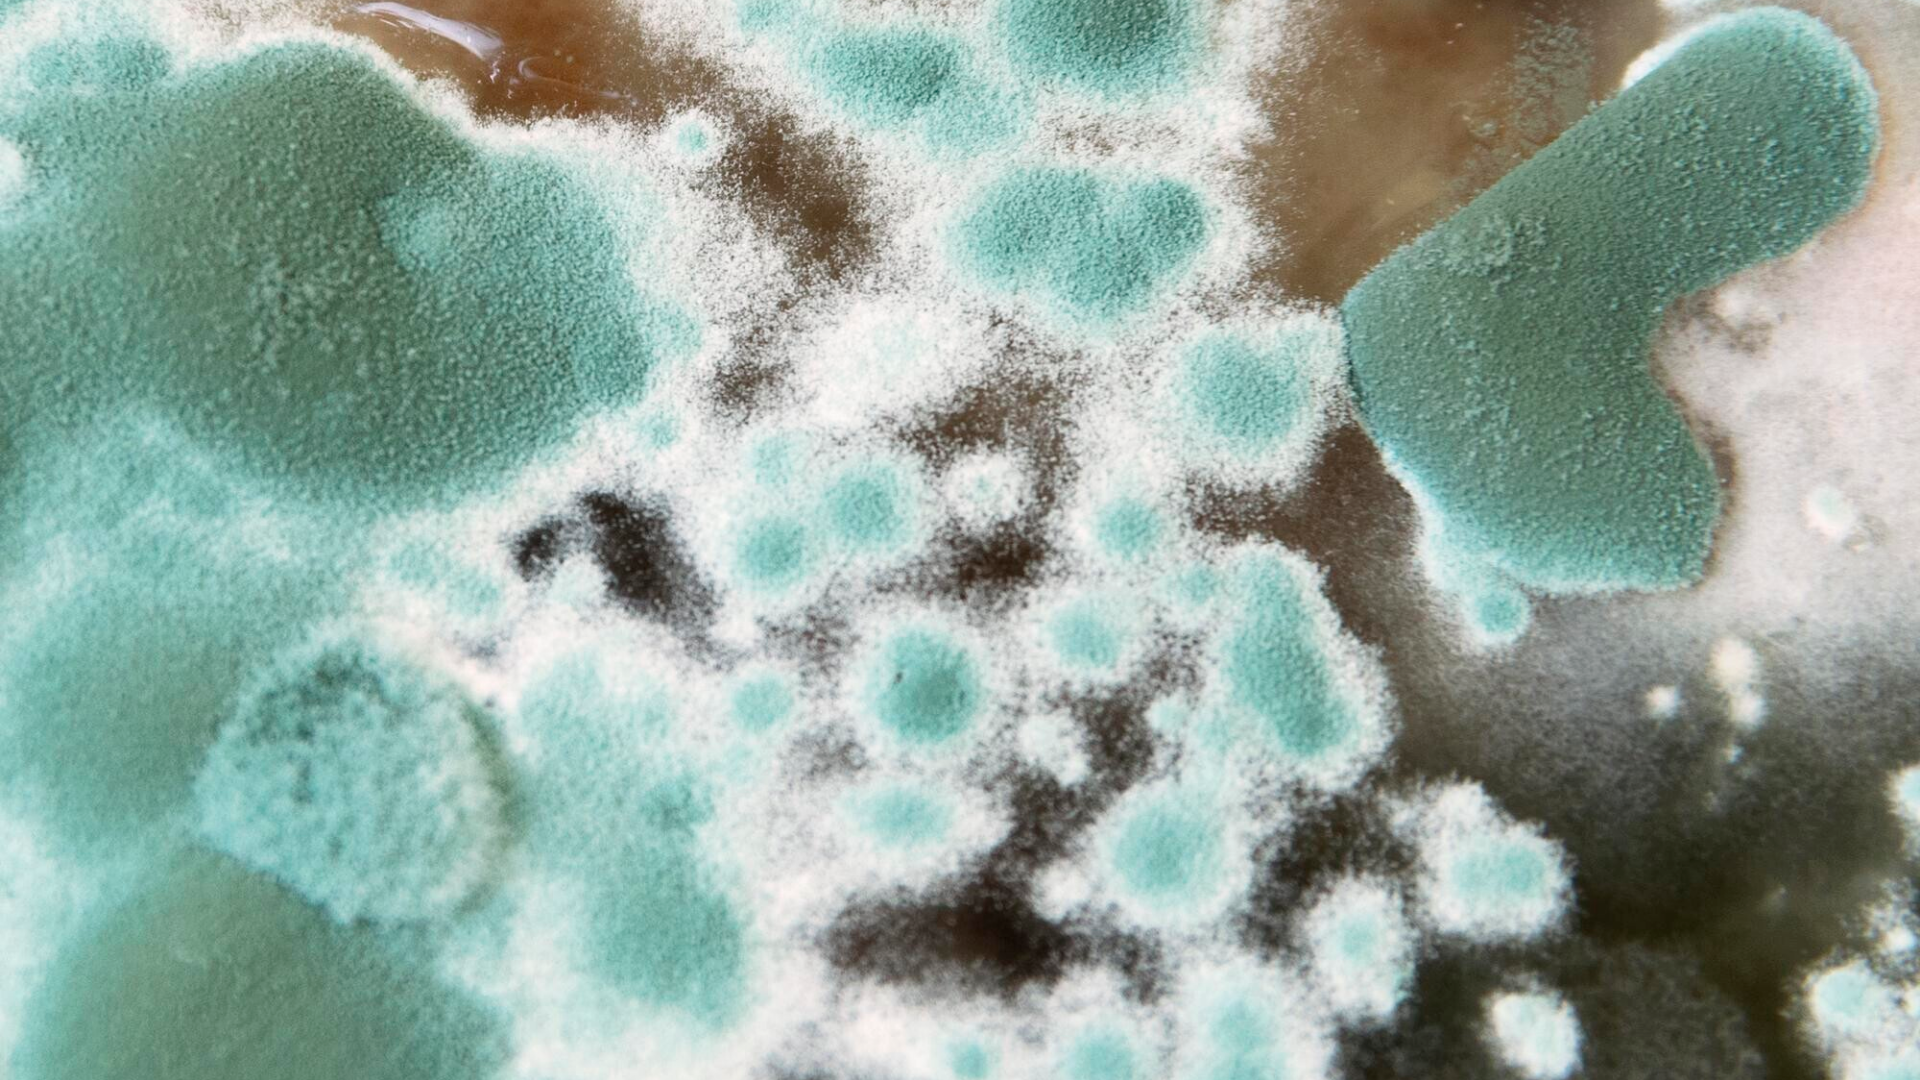
Nấm mốc là tên gọi chung của nhóm nấm vi sinh dạng sợi phát triển bằng cách tạo ra bào tử rất nhỏ và nhẹ, có thể phát tán trong không khí

Trong điều kiện thời tiết nóng ẩm kéo dài, đặc biệt tại những căn hộ kín ít thông gió tự nhiên, nấm mốc trở thành vấn đề phổ biến. Chỉ cần tường thấm nước, điều hòa lâu ngày không vệ sinh hoặc quần áo ẩm không được phơi kịp thời là nấm mốc có thể xuất hiện và lan rộng. Nếu không kiểm soát sớm, chúng không chỉ gây hư hại vật dụng mà còn âm thầm đe dọa sức khỏe mỗi thành viên.
Nấm mốc là gì?
Nấm mốc là tên gọi chung của nhóm nấm vi sinh dạng sợi phát triển bằng cách tạo ra bào tử rất nhỏ và nhẹ, có thể phát tán trong không khí. Khi các bào tử này gặp điều kiện thuận lợi, chúng phát triển thành các mảng mốc màu xanh, đen, trắng, xám hoặc cam trên bề mặt vật liệu.
Nấm mốc phát triển mạnh khi có đủ các yếu tố sau:
Trước hết, cần có độ ẩm cao và nguồn dinh dưỡng hữu cơ. Dưới đây là các điều kiện khiến nấm mốc sinh sôi nhanh chóng:
- Độ ẩm không khí vượt từ 60 đến 70 phần trăm hoặc cao hơn.
- Nhiệt độ trong khoảng từ 20 đến 30 độ C.
- Bề mặt có nguồn dinh dưỡng từ bụi bẩn, gỗ, giấy, vải hoặc tế bào da.
- Không gian thiếu thông gió, bụi bẩn lưu cữu lâu ngày.
Tại Việt Nam, khí hậu nhiệt đới gió mùa với độ ẩm trung bình quanh năm thường trên mức 80 phần trăm tạo môi trường lý tưởng cho nấm mốc. Một vết nứt nhỏ trên tường, khu vực tủ quần áo bị ẩm lâu ngày hoặc thiết bị lạnh không vệ sinh định kỳ đều là vị trí dễ xuất hiện nấm mốc.
Bạn có thể nhận biết nấm mốc qua mùi ẩm khó chịu, các vệt loang màu đen trên tường, vệt mốc tại khe gạch nhà tắm hoặc lớp màng mốc trên thực phẩm để lâu. Những mảng mốc này liên tục phát tán bào tử vào không khí và có thể gây ảnh hưởng trực tiếp đến sức khỏe khi hít phải.
Tác hại của nấm mốc đối với sức khỏe và môi trường sống
Sự xuất hiện của nấm mốc trong nhà không chỉ làm giảm thẩm mỹ mà còn gây ra nhiều vấn đề sức khỏe nghiêm trọng, đặc biệt với trẻ em, người lớn tuổi và người có bệnh hô hấp.
Trước hết, nấm mốc là một trong những tác nhân có thể gây dị ứng. Khi cơ thể tiếp xúc với bào tử nấm, hệ miễn dịch phản ứng bằng cách tạo ra các dấu hiệu như:
- Hắt hơi liên tục.
- Chảy nước mũi và ngứa mắt.
- Nổi mẩn đỏ hoặc viêm da kéo dài.
- Cảm giác khò khè hoặc thở rít nhẹ.

Ở những người mắc hen suyễn hoặc viêm mũi dị ứng, nấm mốc có thể kích hoạt cơn hen tái phát nặng hơn. Tình trạng khó thở về đêm, ho kéo dài hoặc nặng ngực có thể xuất hiện thường xuyên hơn khi sống trong môi trường có nấm mốc cao.
Một số loài nấm như Aspergillus, Penicillium và Stachybotrys chartarum có khả năng sản sinh độc tố nấm gây ảnh hưởng bất lợi đến sức khỏe. Các độc tố này khi hít phải trong thời gian dài có thể:
- Gây tổn thương gan và thận.
- Làm suy giảm miễn dịch.
- Tăng nguy cơ viêm phế quản mạn hoặc viêm xoang kéo dài.
- Tăng nguy cơ tổn thương tế bào về lâu dài.
Ngoài tác động lên sức khỏe, nấm mốc còn gây hư hại môi trường sống bằng cách phá hủy lớp sơn, làm mục gỗ, bong tường, hỏng sách vở hoặc quần áo. Những căn hộ kín gió hoặc sử dụng điều hòa liên tục thường gặp tình trạng nấm mốc nặng hơn do không khí ít được trao đổi.
Cách phòng tránh và xử lý nấm mốc an toàn và hiệu quả tại nhà
Phòng tránh nấm mốc là quá trình kết hợp giữa kiểm soát độ ẩm, vệ sinh thường xuyên và tăng cường thông gió. Nói cách khác, bạn càng tạo ra môi trường khô thoáng thì càng hạn chế nguy cơ nấm mốc sinh sôi. Dưới đây là các biện pháp mà bạn có thể tham khảo:
Giữ không gian sống luôn thoáng khí
Trước khi đi vào các bước cụ thể, hãy ưu tiên tạo điều kiện để không khí trong nhà lưu thông tốt hơn. Điều này giúp giảm độ ẩm và ngăn nấm mốc phát triển.
- Mở cửa sổ mỗi ngày vào thời điểm khô ráo.
- Sử dụng quạt thông gió tại nhà bếp và nhà vệ sinh sau khi nấu ăn hoặc tắm rửa.
- Hạn chế để quần áo ướt trong phòng kín.
- Tránh phơi đồ trong phòng có điều hòa.
Kiểm soát độ ẩm ổn định
Giữ độ ẩm dưới mức 50% được xem là một nguyên tắc quan trọng để hạn chế nấm mốc.
- Sử dụng máy hút ẩm cho khu vực có độ ẩm cao.
- Dùng máy lọc không khí có chức năng giảm ẩm.
- Lau khô sàn và tường sau khi lau nhà hoặc sau khi tắm.
- Xử lý ngay các vị trí thấm nước, rò rỉ từ trần hoặc tường.

Vệ sinh định kỳ thiết bị và bề mặt
Các thiết bị trong nhà dễ tích tụ bụi và ẩm cần được vệ sinh đều đặn.
- Rửa lưới lọc điều hòa từ một đến hai tháng một lần.
- Lau sạch gioăng cao su tủ lạnh và kệ tủ.
- Chà sạch khe gạch nhà tắm hàng tuần.
- Bỏ thực phẩm cũ trong tủ lạnh sau từ ba đến bốn ngày.
Xử lý nấm mốc mức độ nhẹ
Đối với nấm mốc mới xuất hiện và có diện tích nhỏ:
- Dùng giấm trắng pha loãng theo tỉ lệ từ một đến một với nước để lau.
- Kết hợp baking soda để vệ sinh các bề mặt gồ ghề.
- Mang khẩu trang, găng tay và mở cửa sổ khi xử lý để tránh hít phải làm tăng nguy cơ mắc bệnh hô hấp.

Trong trường hợp nấm mốc lan rộng hoặc xuất hiện tại vị trí khó tiếp cận, bạn cần sự hỗ trợ chuyên môn.
- Diện tích nấm mốc lớn hơn một mét vuông.
- Mảng mốc màu đen đậm và lan nhanh.
- Xuất hiện tại trần nhà hoặc tường chịu lực.
- Có dấu hiệu thấm nước kéo dài nhiều tuần.
Cố gắng tự cạo bỏ mảng mốc lớn có thể làm bào tử phát tán mạnh hơn, gây hại cho sức khỏe và làm tình trạng nặng thêm.
Trên đây là thông tin về tác hại của nấm mốc và cách phòng tránh hiệu quả cho sức khỏe mà bạn có thể tham khảo. Nấm mốc là vấn đề phổ biến nhưng không nên xem nhẹ bởi những tác động tiêu cực đến sức khỏe và môi trường sống. Một môi trường sống sạch và không có nấm mốc chính là yếu tố quan trọng giúp bạn và gia đình duy trì sức khỏe lâu dài.
:format(webp)/470051785_8767135473405056_691967411107495592_n_6b2bbff755.png)
:format(webp)/467434554_545745841560409_1066418224364723785_n_560a494f9c.png)
/benh_a_z_thap_tim_4bde5e6fdc.jpg)
/tien_tieu_duong1_533c37142e.jpg)
/cac_loai_rau_pho_bien_va_gia_tri_dinh_duong_nen_biet_6032259529.png)
/tieu_duong_co_an_duoc_banh_gai_khong_nhung_dieu_can_biet_0_ab65579cb5.png)
/tieu_duong_co_an_duoc_thit_bo_khong_nhung_dieu_can_luu_y_0_c374929b19.png)